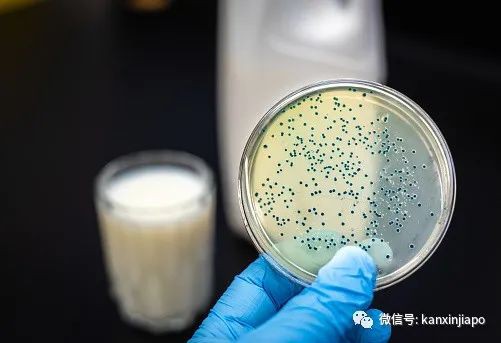
中国官方确认了！“不小心” 使用过期消毒剂，上千人因此受害

中国官方确认了!“不小心” 使用过期消毒剂,上千人因此受害
9月15日晚上,中国甘肃省兰州市官方确认了兰州生物药厂发生泄漏事故。据了解这起事故是在2019年底发生,上千在西北地区的人士因此感染了布鲁氏菌。官方表示,受影响的病患会在10月陆续收到相应的补偿。
根据兰州的卫生健康委员会于9月18日发表的言论,该疾病的主要传染源为牛、羊和猪等牲畜,人类因接触到动物组织或食用乳制品而感染。
(图源:pixabay)
去年的7月至8月之间,兰州生物药厂在制造布菌疫苗时使用了过期的消毒剂,从而导致灭菌工作出现问题。携带含菌发酵液的废气形成含菌气溶胶,透过风传播。这导致中国农科院兰州兽研所出现人体接触,产生抗体阳性。有203名人员检测抗体呈阳性,1名出现临床症状。 (图源:pixabay)截止8月,3245人确认感染布菌病毒。据了解,受影响的人超过4000,甘肃官方对逾2万人员进行检测,阳性者有4646人。若感染布菌病,病症包括发高烧、关节炎、疼痛等。目前没有任何研究显示病毒可通过人类传播,但若感染,一些病症有可能是永久的,如反复发烧等。
(图源:pixabay)截止8月,3245人确认感染布菌病毒。据了解,受影响的人超过4000,甘肃官方对逾2万人员进行检测,阳性者有4646人。若感染布菌病,病症包括发高烧、关节炎、疼痛等。目前没有任何研究显示病毒可通过人类传播,但若感染,一些病症有可能是永久的,如反复发烧等。 (图源:pixabay)虽然甘肃官方把这起事故定位为一场意外,涉事企业和相关负责人还是接受了严厉的惩罚。兰州生物药厂布菌病疫苗生产车间已在去年12月7日关闭。另外,公司的布病疫苗生产执照也在今年1月13日被撤销。
(图源:pixabay)虽然甘肃官方把这起事故定位为一场意外,涉事企业和相关负责人还是接受了严厉的惩罚。兰州生物药厂布菌病疫苗生产车间已在去年12月7日关闭。另外,公司的布病疫苗生产执照也在今年1月13日被撤销。



















评论